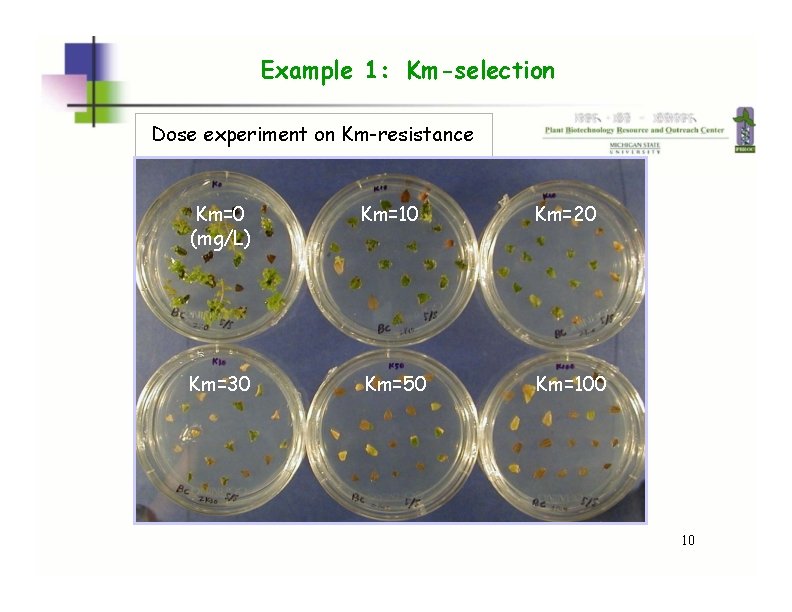
Example 1: Km-selection Dose experiment on Km-resistance Km=0 (mg/L) Km=10 Km=20 Km=30 Km=50 Km=100 Example 1: Km-selection Dose experiment on Km-resistance Km=0 (mg/L) Km=10 Km=20 Km=30 Km=50 Km=100
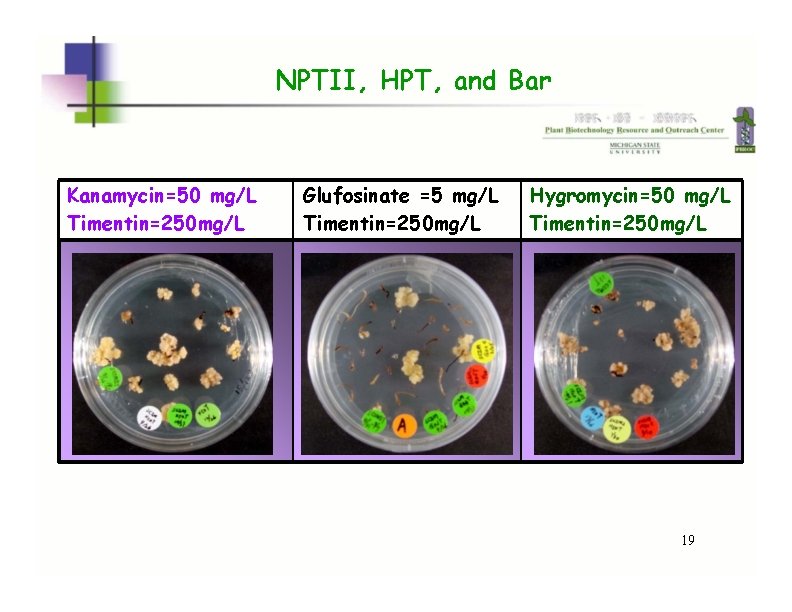
NPTII, HPT, and Bar Kanamycin=50 mg/L Timentin=250 mg/L Glufosinate =5 mg/L Timentin=250 mg/L Hygromycin=50 NPTII, HPT, and Bar Kanamycin=50 mg/L Timentin=250 mg/L Glufosinate =5 mg/L Timentin=250 mg/L Hygromycin=50

Selectable Markers Markers for Screening Guoqing Song David

Selectable Markers & Markers for Screening Guo-qing Song & David Douches 1 January 2009

Marker gene A marker gene is used in molecular biology to determine if a piece of DNA has been successfully inserted into the host organism. There are two types of marker genes: selectable markers and markers for screening. 2

selectable markers and markers for screening 4

Selectable markers & Markers for screening • • • A selectable marker will protect the organism from a selective agent that would normally kill it or prevent its growth. In most applications, only one in a several million or billion cells will take up DNA. Rather than checking every single cell, scientists use a selective agent to kill all cells that do not contain the foreign DNA, leaving only the desired ones. Antibiotics are the most common selective agents. In bacteria, antibiotics are used almost exclusively. In plants, antibiotics that kill the chloroplast are often used as well, although tolerance to salts and growth-inhibiting hormones is becoming more popular. A marker for screening will make cells containing the gene look different. There are three types of screening commonly used: Green fluorescent protein (GFP) makes cells glow green under UV light. A specialized microscope is required to see individual cells. Yellow and red versions are also available, so scientists can look at multiple genes at once. It is commonly used to measure gene expression. GUS assay (using β-glucuronidase) is an excellent method for detecting a single cell by staining it blue without using any complicated equipment. The drawback is that the cells are killed in the process. It is particularly common in plant science. Blue/white screening is used in bacteria. The lac. Z gene makes cells turn blue in special media (e. g. X-gal). A colony of cells with the gene can be seen with the naked eye. 4

Literature Miki, B. , Mc. Hugh, S. Selectable Marker Genes in Transgenic Plants - Applications, Alternatives and Biosafety. Journal of Biotechnology. 2004. 107(3): 193 -232. Hare, P. , Chua, N. Excision of Selectable Marker Genes from Transgenic Plants. Nature Biotechnology. 2002. 20(6): 575 -580. Goldstein et al. A Review - Human Safety and Genetically Modified Plants - A Review of Antibiotic Resistance Markers and Future Transformation Selection Technologies. Journal of Applied Microbiology. 2005. 99: 7 -23. Ramessar, K. , Peremarti, A. , Gomez-Galera, S. , Naqvi, S. , Moralejo, M. , Munoz, P. , Capell, T. , Christou, P. Biosafety and Risk Assessment Framework for Selectable Marker Genes in Transgenic Crop Plants: A Case of the Science Not Supporting the Politics. Transgenic Research. 2007. 16(3): 261 -280. 5

Selectable Markers 6

Selectable Markers • About 50 selectable marker genes • Six negative SMG: cod. A, aux 2, tms 2, dhl. A, CYP 105 A, and cue • npt. II, hpt, and bar contribute to over 95% transgenic plants • pmi (the E. coli man. A): mannose-dependent SMG production of 7 Miki & Mc. Hugh, J. Biotech. 2004, 107: 193 -232

Marker genes listed in US field test notifications and release permits for the years 2001 and 2002 (data extracted from ISB, 2003) Enzyme Number of records in 2001 and 2002 Neomycin phosphotransferase II (NPT II) Hygromycin B phosphotransferase (hpt) 949 65 Phosphinothricin N-acetyltransferase (PAT) 327 5 -Enolpyruvylshikimate-3 -phosphate (EPSP) synthase 507 Acetolactate synthase or acetohydroxyacid synthase 5 Nitrilase 0 Cyanamide hydratase 2 Glucuronidase (GUS) 91 Luciferase 4 Green fluorescent protein (GFP) 20 93. 8% 8 Miki & Mc. Hugh, J. Biotech. 2004, 107: 193 -232

NPT II—Kanamycin (Km) resistance • • • NPT II = neomycin phosphotransferase II Normally, plant cells are sensitive to Km. Km inhibits protein synthesis and protein translocation across membranes. • Expression of the NPTII in plant cells results in synthesis of NPTII enzyme The enzyme detoxifies Km by phosphorylation • ATP Km (Disrupts plant growth) ADP NPTII enzyme Km-PO 4 (Unable to disrupts plant growth) Km-resistant Km-sensitive 9
Example 1: Km-selection Dose experiment on Km-resistance Km=0 (mg/L) Km=10 Km=20 Km=30 Km=50 Km=100 10

Example 1: Km-selection Km= 0 mg/L Km= 25 mg/L Non-transformed Explants Transformed Explants Inoculation Selection & Regeneration 12 Song and Sink. Plant Cell Reports (2004)

Bar-Phosphinothricin (PPT) resistance • • PPT normally acts to inhibit glutamine synthetase, causing a fatal accumulation of ammonia PAT belongs to the family of acetyltransferases. It detoxifies PPT by catalysing the addition of an acetyl group to the free amino group ATP, NH 3 Non-trangenic ADP, PI Glutamine Glutamate Glutamine Synthase Rapid accumulation of ammonia which lead to death of the plant cell Inhibiting GS PPT Trangenic PAT Acetyl-PPT 12

Example 2: PPT-selection 2 wk, 5 mg/L ppt PPT = 0. 2 mg/L 13

Chlorophenol red assay 2 wk, 5 mg/L ppt L 18 WT L 21 L 25 L 22 Transgenic L 28 15 Song et al. Acta Horticulturae 738: 397 -408 (2007)

Example 2: PPT-resistance PPT=7500 ppm, 1 week NT L 18 16 Song et al. JASHS. (2008)

Example 2: PPT-resistance 16

Hpt, hph or aph. IV-Hygromycin (Hyg) B resistance The hygromycin phosphotransferase (denoted hpt, hph or aph. IV) gene was originally derived from Escherichia coli. The gene codes for hygromycin phosphotransferase (HPT), which detoxifies the aminocyclitol antibiotic hygromycin B. A large number of plants have been transformed with the hpt gene and hygromycin B has proved very effective in the selection of a wide range of plants, including monocotyledonous. Most plants exhibit higher sensitivity to hygromycin B than to kanamycin, for instance cereals. Likewise, the hpt gene is used widely in selection of transformed mammalian cells. Like kanamycin and other aminoglycoside antibiotics, hygromycin B inhibits protein synthesis by interfering with m. RNA translation and causing mistranslocation of m. RNA. 17

Example 3: Hyg-selection Hyg-Selection (50 mg/L) Hyg-Selection & Regeneration (50 mg/L) 18
NPTII, HPT, and Bar Kanamycin=50 mg/L Timentin=250 mg/L Glufosinate =5 mg/L Timentin=250 mg/L Hygromycin=50 mg/L Timentin=250 mg/L 19

Friendly SMG Advantages: Non toxic Rapid and efficient Trait stacking Address public concern The Positech. TM by Syngenta maize, rice, wheat, barley, cassava, sugar beet, watermelon, tomato, squash, cabbage, sunflower, oilseed rape, sweet orange, almond, papaya, and apple 21

Mannose ATP mannitol-1 phosphate PO 4 Pase 3 M 6 PR 2 mannose-6 -phosphate NADPH PMI 1 phosphate deficiency fructose-6 -phosphate mannitol NADH fructose Mtd 4 metabolism 1– PMI, phosphomannose isomerase activity is low in some plants, and apparently absent in others, grasses like wheat, rice, corn, and sorghum. Gene for this enzyme is also known as man. A. 2– M 6 PR, mannose-6 -phosphate reductase, is present in some higher plant families 3– non-specific phosphatases, Pases, are present in nearly all higher plants. This releases phosphate otherwise sequestered in mannose and mannitol phosphate 4– Mtd, mannitol dehydrogenase, is present in nearly all higher 22 plants

Other SMG Isopentyl transferases Histidine kinase homologue Hairy root-inducing genes 22

Markers for Screening 23

GUS: beta-glucuronidase 5 -bromo-4 -chloro-indolyl glucuronide ( X -gluc): Colorless 4 -methyl-umbelliferyl-beta-D-glucuronide ( Beta-glucuronidase + X -Gluc 37 C X + Hydrolysis of the X-Gluc substrate by the GUS enzyme + Gluc -gluc) O 2 The GUS histochemical staining assay Dimerization of the Gluc product by reaction with O 2 Beta-glucuronidase + -Gluc 37 C + Hydrolysis of the X-Gluc substrate by the GUS enzyme + Gluc Fluorescent of the released fluorescent product Fluorogenic staining 25 Ruijter et al. , 2003, Plant Biology, 5: 103 -115

The GUS Histochemical Staining Assay Blueberry Sweettppoottato Celery WT WT Stem WT WT WT 26 Song GQ & Sink KC. Plant Cell, Tissue and Organ Culture 88: 193 -200 (2007)

The GUS Histochemical Staining Assay Rice Evaluation of different promoters 26

Luciferase (LUC) A conditional non-selectable marker gene 27

Firefly Luciferase (ff-LUC) In the absence of Co. A the protein is inactivated by complex formation with oxyluciferin and the reaction is non-enzymatic (the “so-called” flash reaction) + Oxyluciferin Co A, O 2, AT P In the presence of the luciferase protein is rapidly released from the complex, resulting in an enzymatic reaction O 2, ATP Oxyluciferin. AMP + PPi + CO 2 + Oxyluciferin. Co. A Oxyluciferin AMP + PPi + CO 2 28

Green Fluorescent Protein (GFP) The great advantage of GFP as a non-conditional reporter is the direct visualization of GFP in living cells in real time without invasive procedures such as the application or penetration of cells with substrate and products that may diffuse within or among cells. Both considerations provide a significant improvement over GUS and LUC as reporter genes. 29

GFP In 1994 GFP was cloned. Now GFP is found in laboratories all over the world where it is used in every conceivable plant and animal. The GFP gene can be introduced into organisms and maintained in their genome through breeding, or local injection with a viral vector which can be used to introduce the gene. 30

Green Fluorescent Protein (GFP) The GFP is composed of 238 amino acids, originally isolated from the jellyfish Aequorea victoria that fluoresces green when exposed to blue light. Martin Chalfie, Osamu Shimomura and Roger Y. Tsien were awarded the 2008 Nobel Prize in Chemistry on 10 December 2008 for their discovery and development of the green fluorescent protein. 32

GFP O 2 Fluorescent of GFP Formation of the chromophone requires molecular oxygen 33 Ruijter et al. , 2003, Plant Biology, 5: 103 -115

GFP A Transgenic embryoid of Valencia sweet orange; bar = 200 μ m. B Transgenic plant of Valencia sweet orange in the greenhouse. C GFP expression in shoot tip of a transgenic Valencia plant; bar = 1 mm 34 Guo et al. , Plant Cell Rep. 2005, 24: 482 -486

By Sam Gross, 1991 By Sam Gross, 1997 Genetic engineering got us into this mess, and genetic engineering will get us out of it. ” By Sam Gross, 1999 NEXT ? 35

Marker-free Strategies 35

Concerns about the SMG Although no adverse biosafety effects have been reported for the marker genes that have been adopted for widespread use, biosafety concerns should help direct which markers will be chosen for future crop development. Common sense dictates that marker genes conferring resistance to significant therapeutic antibiotics could not be used. 36

Marker-free Strategies 1. Co-transformation and segregation of marker genes 2. Transposon-mediated repositioning of genes 3. Intrachromosomal homologous recombination to remove SMG 4. Site-specific recombinase-mediated excision of marker genes 37 Miki & Mc. Hugh. J. Biotech. 2004, 193 -232

Marker-free Strategies 1. Co-transformation and segregation of marker genes • Co-transformation with separate plasmids in one or two Agrobacterium strains • Co-transformation with single plasmids carrying multiple T-DNA regions An advantage of Agrobacterium-mediated co-transformation technologies over biolistic transformation is that the cotransformation genes often integrate into differernt loci in plant genome. 38 Miki & Mc. Hugh. J. Biotech. 2004, 193 -232

Marker-free Strategies 4. Site-specific recombinase-mediated excision of marker genes • The Cre-Lox. P System (bacteriophage) • The FLP-FRT System (yeast) • The R-RS System Cre, FLP and R are the recombinases, and lox. P, FRT and RS are the recombination sites. 39

Marker-free Strategies Figure 1. Recognition sites for recombinases shown to function in plants share a similar design. All comprise palindromes, which flank the six to eight innermost base pairs. Each recombinase binding element (RBE) is bound by a single recombinase subunit. Cleavage of the sites occurs at the borders between the RBEs and the core sequence. The core element is the site of strand exchange and confers directionality on the recombination site. Recombination requires two recombinase recognition sites bound by four identical recombinase subunits. 41 Peter D. Hare & Nam-Hai Chua. Nature Biotechnology 20, 575 - 580 (2002) Excision of selectable marker genes from transgenic plants

Marker-free Strategies Integration Selection with SMG LB Loxp FRT RS X npt. II hpt bar SMG Cre Flp R Ind Loxp FRT RS Target gene X TG RB Excision of SMG RB LB SMG Ind TG 41
- Slides: 41